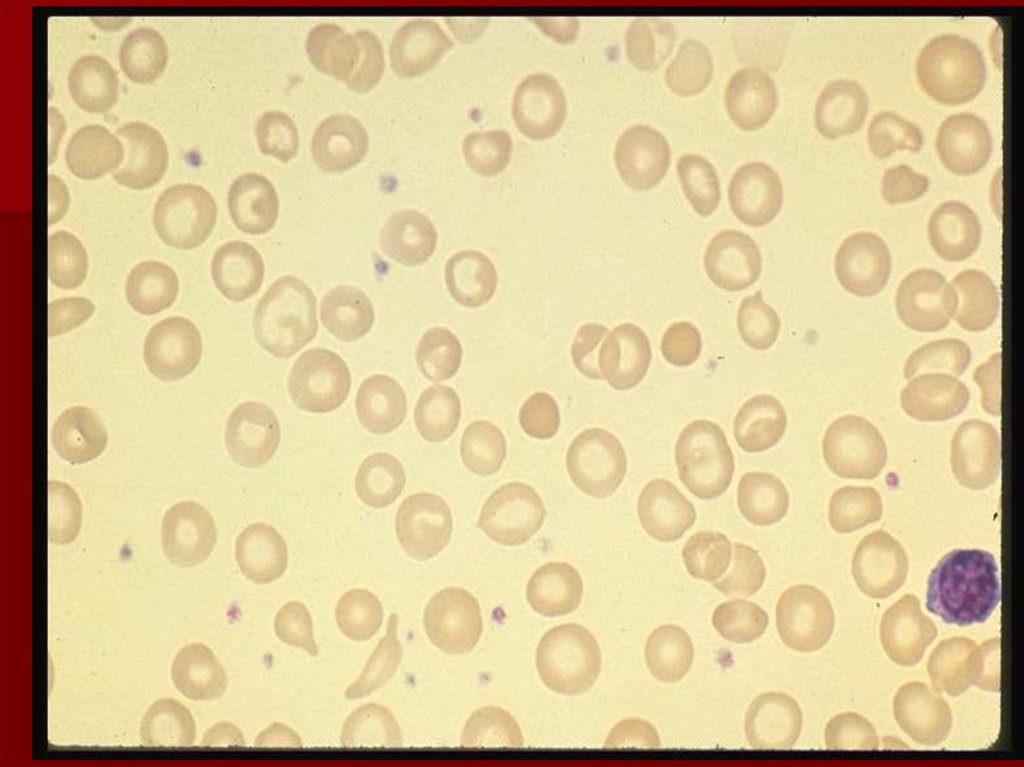
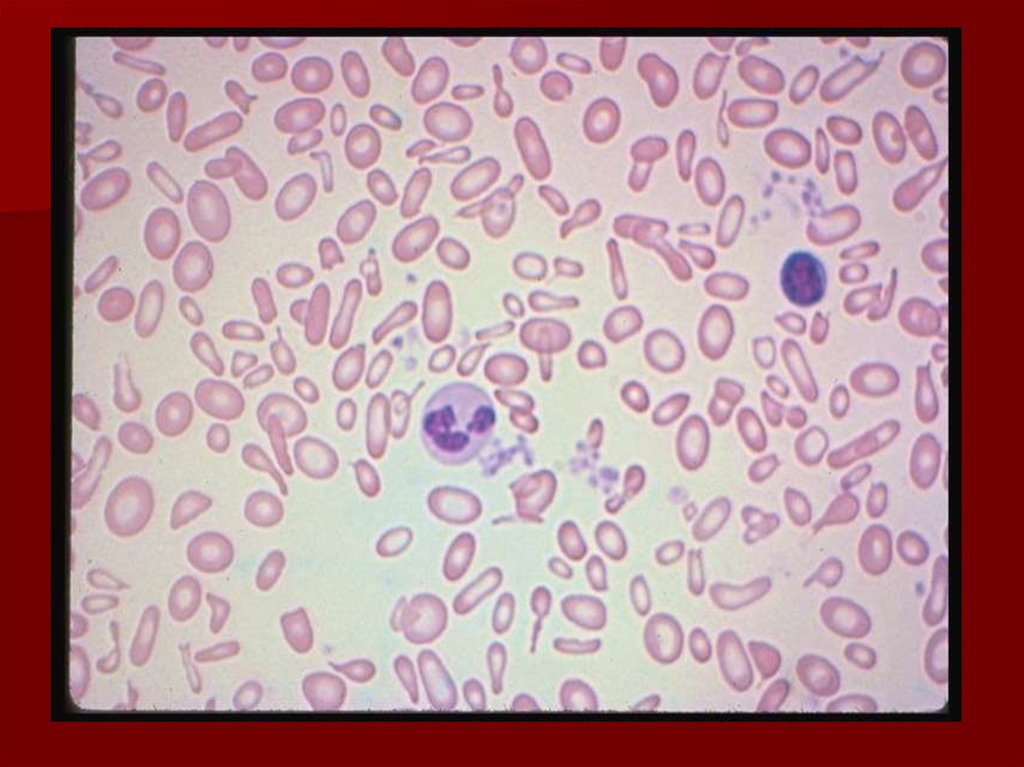
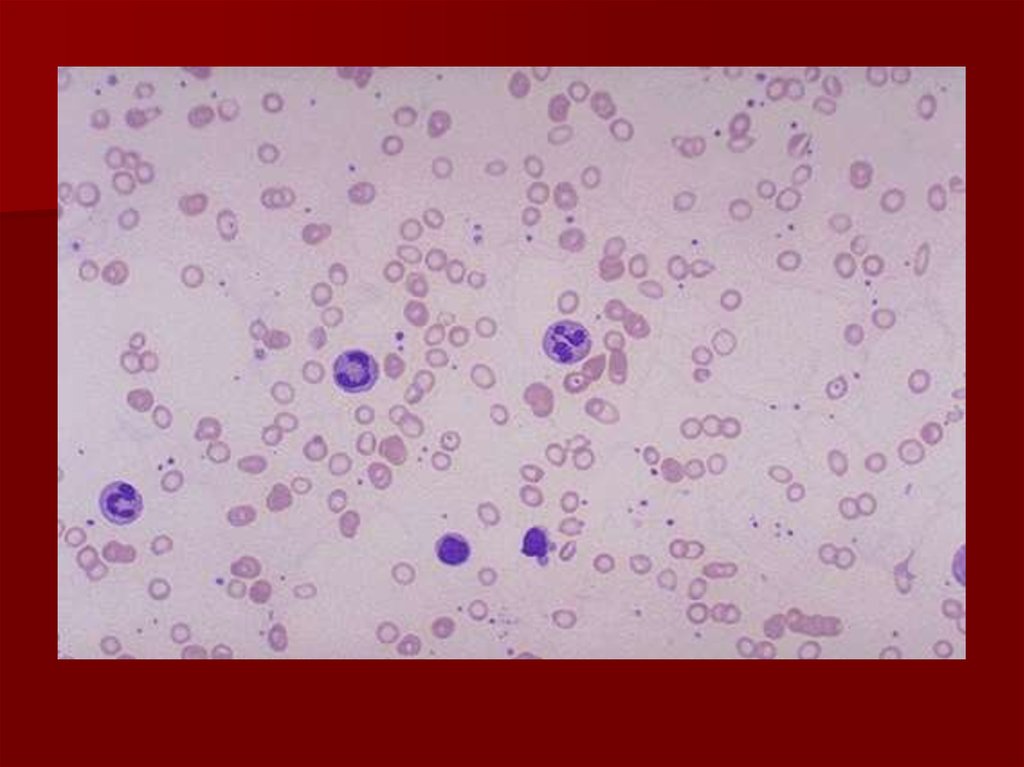

Similar presentations:
Қан түзілуідің бұзылуынан болатын анемиялардың дифференциялық диагностикасы
1. Қан түзілуідің бұзылуынан болатын анемиялардың дифференциялық диагностикасы
2. Темір тапшылықты анемия
1)Қан сарысуында қордағы теміржетіспеушілігінен дамитын анемия
2)Инфекциялық аурулардың себебінен
дамитын темір тапшылықты анемия.
3)Порферин таралуы мен синтезінің
бұзылысына байланысты темір
тапшылықты анемия.
3. 1)Қан сарысуында және қордағы темір жетіспеушілігінен дамитын анемия
4. Себебі
Ас қорту жолдарының аурулары(асқазан, онекелішектің эрозиялары,
жаралары, ішектің рагы өңештің
рагы.)
Мұрынның жиі қанауы.
Геморрагиялық диатез.
Гемобластоздар
Темір сіңірілудің бұзылуы;
Темірді көп мөлшерде жұмсау;
Темірдің тамақпен аз мөлшерде түсуі;
Темірдің ағзаға дұрыс таралмауы.
5.
Клиникалық көрінісі1.Сидеропениялық синдром.
• Терімен тері өсінділерінің
дистрофиясы
• Терінің құрғауы
• Шаштың түсуі
• Тырнақтардың жұқаруы,
сынғыштығы
• Тілдің ашып ауруы.
6. Клиникалық көрінісі
2.Анемиялық синдромӘлсіздік
Еңбекке қабілетінің төмендеуі
Тері және кілегей қабаттарының
бозаруы
Бауырдың ұлғаюы
Гипоксия
Тахикардия, ентігу
7.
8.
Лабораториялык өзгерістері:•Hb төмендеуі
•Гипохромды анемия
•Микроцитоз,пойкило-анизоцитоз
•Сүйек миында эритробластардың
санының жоғарлауы.
•Сары суда темірдің төмендеуі (1,85,4 ммоль/л)
•Феретин деңгейінің төмендеуі.
9. Темір тапшылықты анемияның микроскопиялык көрінісі
10.
11.
12.
13. Инфекциялық аурулардың себебінен дамитын темір тапшылықты анемия.
14. Себебі
СепсисТуберкулез
Созылмалы
пиолонефрит
Ревматоидты артрит
Инфекциялық эндокардит
15. Клиникалық көрінісі
1. Сидеропениялық синдром.Терімен тері өсінділерінің
дистрофиясы
Терінің құрғауы
Шаштың түсуі
Тырнақтардың
жұқаруы,сынғыштығы
тілдің ашып ауырсынуы
16. Клиникалық көрінісі
2. Анемиялық синдромӘлсіздік
Еңбекке қабілетінің төмендеуі
Тері және кілегей қабаттарының
бозаруы
Бауырдың ұлғаюы
Гипоксия
Тахикардия, ентігу
17. Лабораториялык өзгерістер:
Әлсіз гемохромды анемияТүс көрсеткіші төмендейді
Гемоглобин 80г/л
Қан сары суында темірдің мөлшері
төмендейді
Қан сарысуында феретин құрамы
жоғарылайды
Сүйек кемігінде сидеробластардың саны
азаяды
18. Порфериннің таралуы мен синтезінің бұзылысына байланысты дамитың темір тапшылықты анемия.
19. Себебі
1.Тұқым қуалаушылық
факторлар:
Порферин синтезінің бұзылуына
байланысты дамитын.
Фермент тапшылығына байланысты
дамитын.
2.
Жүре пайда болған:
В6 витамин жетіспеушілігінен дамитын
20. Клиникасы
АритмияЖүрек ұшында систолиялық шу
Миокардтың зақымдануы
Қан айналым жеткіліксіздігі
Айқын ентігу
Аяқтарда ісіну болады.
21. Лабараторияда
Қан анализінде:Гемоглобин 50-60г/л төмендейді
Түс көрсеткіші төмендейді
Ретикулациттер төмендейді
Пойкилоцитоз
Қан сары суында темір және феретин
деңгейі жоғарылайды
22. Лабараторияда
Бауырдың зақымдануы кезінде екіншілікхромоцитоз
қан құрамында билирубин
аминотрансфераза, сілтіліфосфотаза деңгейі
жоғарылайды
албумин деңгейі төмендейді.
23. Аспаптық зерттеулерде
ЭКГ: Т-тісшесінің амплитудасы төмендейдіжәне SТ-интервалы изосызықтан төмен.
УЗИ: Екіншілік гемохраматоз кезінде
бауыр, жүректің өлшемдері ұлғаяды.

medicine
medicine








